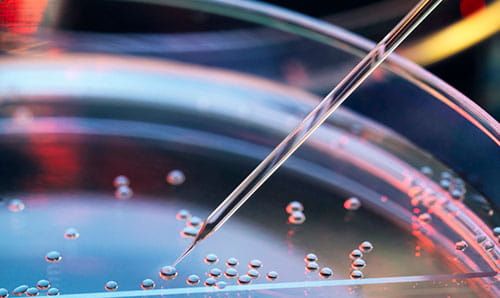
committed to innovation

For medical professionals resources
At Allina Health, we are a physician-led, not-for-profit health care organization, serving communities throughout Minnesota and western Wisconsin. We invest in our physicians and advanced practice clinicians through clinical leadership, advanced technology and strong administrative tools that help free you up so you can do what you do best: care for patients and grow your practice.
Employee COVID-19 testing and ability to work
Employee Occupational Health COVID-19 online intake form, employee testing, and Ability to Work Guidelines
Employees can schedule their COVID-19 test, review the Ability to Work Guidelines, and complete an Employee Occupational Health COVID-19 online intake form. You will need an Allina Health network ID (A# or D#) and password. If you do not have an Allina Health network ID, you can also use an access code provided by provideraccess@allina.com.
Medical staff credentialing and privileging
If you are interested in joining our hospitals use credentialing@allina.com to request an application. To submit an initial or reappointment application log into the Portal with the logon information and password you received from the Allina CVO team.
Provider Enrollment is responsible for enrollment, re-credentialing, terminations of any practitioner who bills professional services at Allina Health System with the 3rd party commercial and government payers/health plans. Learn more about medical staff credentialing and privileging.
Access Excellian
Excellian® is one of the most comprehensive electronic health record (EHR) systems in the nation. For technical assistance, call 612-262-1900612-262-1900 or 1-800-315-40851-800-315-4085. Learn more about accessing Excellian.


Transfer or refer a patient
Our team of experts at Allina Health provide world class care through our multiple centers of excellence. Transfer or refer a patient to Allina Health.

Allina Health Laboratory
Allina Health Laboratory is an integrated, multi-site laboratory that delivers more than five million laboratory services throughout Minnesota and western Wisconsin. Search Allina Health Laboratory test catalog.
Allina Health Research
Allina Health advances research that improves patient outcomes, refines models of health care delivery and enhances population health for the communities we serve.

AIM Network
The Allina Integrated Medical (AIM) Network aligns independent physicians and Allina Health to deliver market-leading quality and efficiency in patient care.

Allina Health Library Services
Library Services is your access point to the latest medical, scientific and research resources. We offer services to help health care professionals answer questions, gain knowledge and make informed decisions using evidence-based research information.

Provider wellness resources
Resources to help providers experience greater satisfaction in their practice, have more satisfied patients and better clinical outcomes and experience less stress and burnout.

Enterprise Medical Imaging
The Enterprise Medical Imaging (EMI) Picture Archiving and Communication System (PACS) application offers providers remote access to X-ray, MRI, CT, ultrasound, cardiovascular and other medical images.

Provider Connect
The Allina Health Provider Connect blog offers timely information and insights from our multispecialty cancer care team.

Physician careers
Ask any doctor why they became a doctor, and the answer is always the same. To make a difference. Let us help you find career opportunities that meet your needs and match your practice style, goals and credentials.

Protocols
Protocol information about stroke and cardiovascular emergencies and orthopedic physical therapy.
OncLive
OncLive offers oncology professionals resources and information to help them further provide excellent patient care.
Applications for employee use
Download trusted applications that make your job easier and keep you connected no matter where your day takes you.

Voting for US News & World Report rankings
Learn how to vote in the magazine’s Best Hospitals rankings..

Business Development Program
The Business Development Team is available to meet in person or virtually to help you build a relationship with Allina Health. Learn more or contact the Business Development Team.
Additional resources
Managing your 'Find a Provider' information
Health care providers affiliated with Allina Health can be in Find a Provider on allinahealth.org and the Allina Health Physician Referral telephone service.
Once submitted and approved, your information will be available to patients and other providers who call 1-888-425-54621-888-425-5462 or visit allinahealth.org.
Complete the provider information form to add, update or remove your information.

